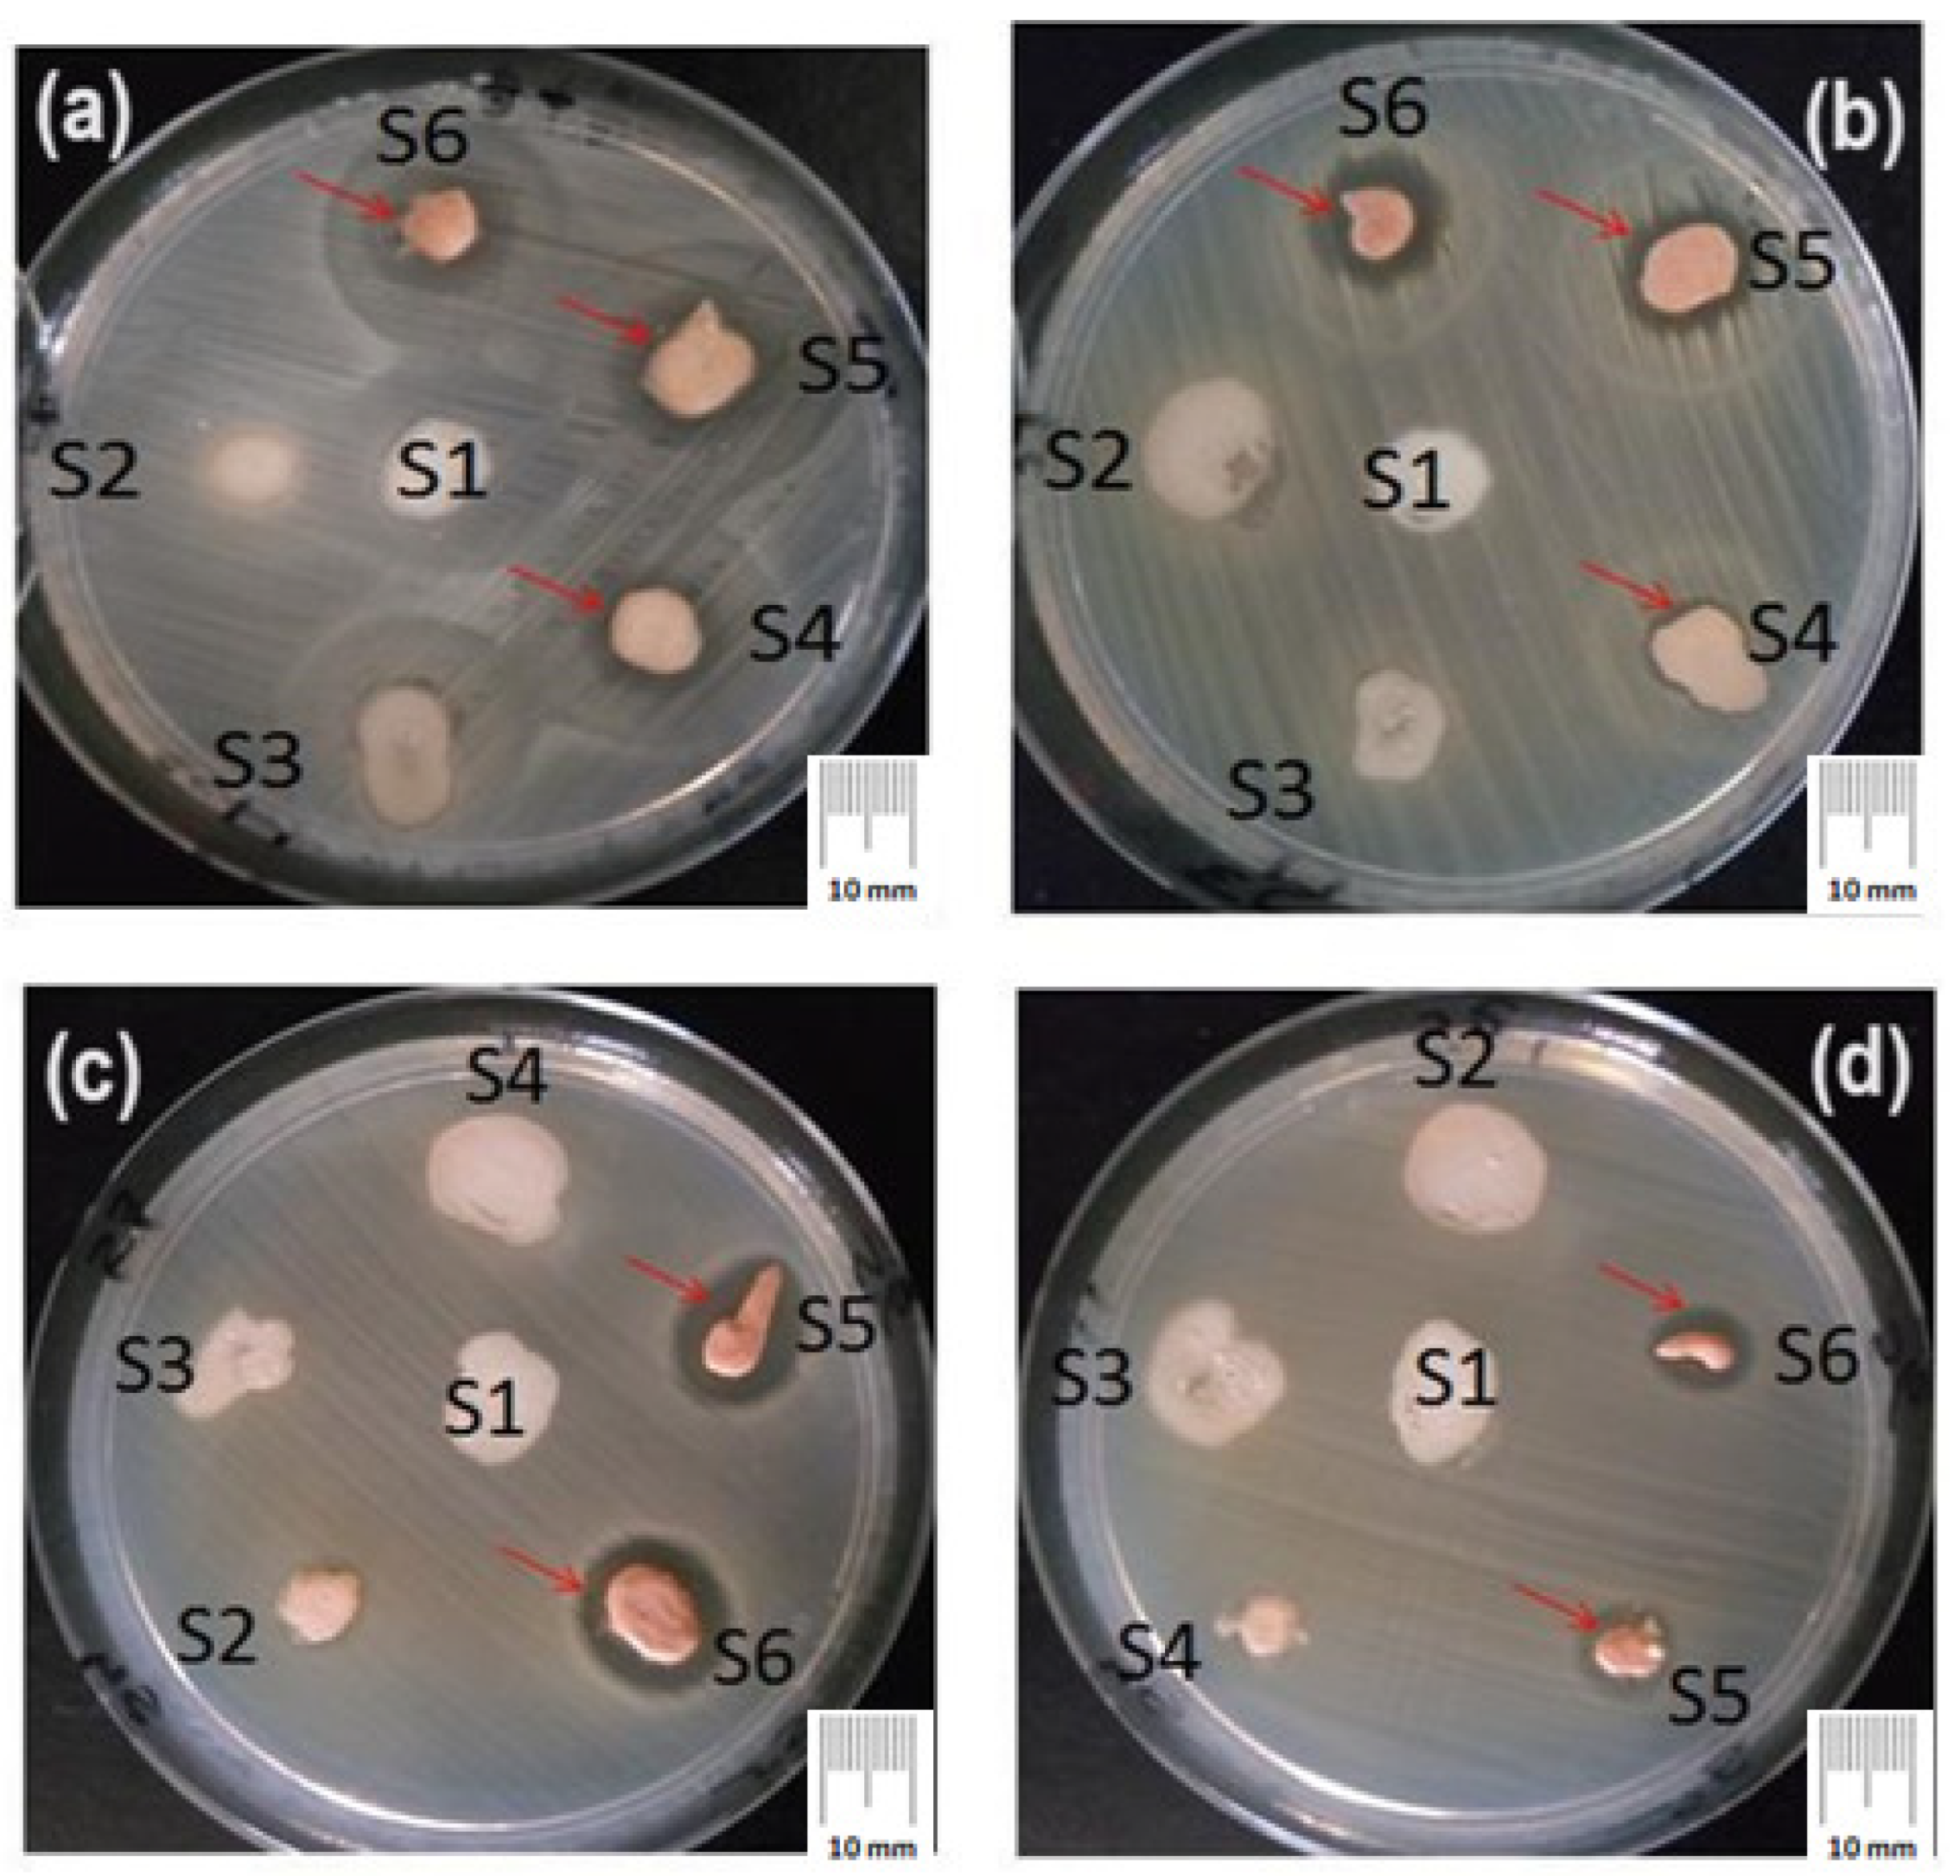
Applsci 14 04612 g007

Green Synthesis of Nanoparticles Containing Zinc Complexes and Their Incorporation in Topical Creams with Antimicrobial Properties
Abstract
1. Introduction
2. Materials and Methods
2.1. Preparation of Aqueous Vine Leaves Extract
2.1.1. Determination of Total Polyphenols Content
2.1.2. Determination of Total Flavonoids Content
2.2. Synthesis and Characterization of the Nanoparticles Containing Zinc Complexes
2.2.1. Synthesis of the Nanoparticles Containing Zinc Complexes
2.2.2. Characterization of the Nanoparticles Containing Zinc Complexes
2.3. Formulation and Evaluation of the Topical Creams That Contain ZnNPs
2.3.1. Formulation of the Creams
2.3.2. Evaluation of the Creams
3. Results and Discussion
3.1. Characterization of Aqueous Vine Leaves Extract
3.1.1. Total Content of Polyphenols from the Aqueous Vine Leaves Extract
3.1.2. Total Flavonoids Content from the Aqueous Vine Leaves Extract
3.2. Characterization of the Nanoparticles Containing Zinc Complexes
3.2.1. SEM/EDX Analysis
3.2.2. XRD Analysis
3.2.3. Fourier Transform Infrared Spectroscopy (FTIR)
3.2.4. DR UV–Visible Analysis
3.2.5. Evaluation of the Creams
Microscopic Analysis of the Creams
Organoleptic Characteristics and Physical-Chemical Properties of the Creams
Skin Irritancy Test
‘In Vitro’ Evaluation of the Antibacterial Activity
4. Conclusions
Author Contributions
Funding
Institutional Review Board Statement
Informed Consent Statement
Data Availability Statement
Conflicts of Interest
References
- Ross, A.A.; Rodrigues Hoffmann, A.; Neufeld, J.D. The Skin Microbiome of Vertebrates. Microbiome 2019, 7, 79. [Google Scholar] [CrossRef] [PubMed]
- Lake, J.G.; Weiner, L.M.; Milstone, A.M.; Saiman, L.; Magill, S.S.; See, I. Pathogen Distribution and Antimicrobial Resistance Among Pediatric Healthcare-Associated Infections Reported to the National Healthcare Safety Network, 2011–2014. Infect. Control Hosp. Epidemiol. 2018, 39, 1–11. [Google Scholar] [CrossRef]
- Rodvold, K.A.; McConeghy, K.W. Methicillin-Resistant Staphylococcus Aureus Therapy: Past, Present, and Future. Clin. Infect. Dis. 2014, 58 (Suppl. S1), S20–S27. [Google Scholar] [CrossRef]
- Kamli, M.R.; Alzahrani, E.A.; Albukhari, S.M.; Ahmad, A.; Sabir, J.S.M.; Malik, M.A. Combination Effect of Novel Bimetallic Ag-Ni Nanoparticles with Fluconazole against Candida Albicans. J. Fungi 2022, 8, 733. [Google Scholar] [CrossRef] [PubMed]
- Nguyen, D.H.; Vo, T.N.N.; Nguyen, N.T.; Ching, Y.C.; Hoang Thi, T.T. Comparison of Biogenic Silver Nanoparticles Formed by Momordica Charantia and Psidium Guajava Leaf Extract and Antifungal Evaluation. PLoS ONE 2020, 15, e0239360. [Google Scholar] [CrossRef]
- Wang, L.; Hu, C.; Shao, L. The Antimicrobial Activity of Nanoparticles: Present Situation and Prospects for the Future. Int. J. Nanomed. 2017, 12, 1227–1249. [Google Scholar] [CrossRef]
- Correa, M.G.; Martínez, F.B.; Vidal, C.P.; Streitt, C.; Escrig, J.; de Dicastillo, C.L. Antimicrobial Metal-Based Nanoparticles: A Review on Their Synthesis, Types and Antimicrobial Action. Beilstein J. Nanotechnol. 2020, 11, 1450–1469. [Google Scholar] [CrossRef]
- Macovei, I.; Luca, S.V.; Skalicka-Woźniak, K.; Horhogea, C.E.; Rimbu, C.M.; Sacarescu, L.; Vochita, G.; Gherghel, D.; Ivanescu, B.L.; Panainte, A.D.; et al. Silver Nanoparticles Synthesized from Abies Alba and Pinus Sylvestris Bark Extracts: Characterization, Antioxidant, Cytotoxic, and Antibacterial Effects. Antioxidants 2023, 12, 797. [Google Scholar] [CrossRef] [PubMed]
- Guignard, M.I.; Campagne, C.; Giraud, S.; Brebu, M.; Vrinceanu, N.; Cioca, L.-I. Functionalization of a Bamboo Knitted Fabric Using Air Plasma Treatment for the Improvement of Microcapsules Embedding. J. Text. Inst. 2015, 106, 119–132. [Google Scholar] [CrossRef]
- Chopra, H.; Bibi, S.; Singh, I.; Hasan, M.M.; Khan, M.S.; Yousafi, Q.; Baig, A.A.; Rahman, M.; Islam, F.; Emran, T.B.; et al. Green Metallic Nanoparticles: Biosynthesis to Applications. Front. Bioeng. Biotechnol. 2022, 10, 874742. [Google Scholar] [CrossRef]
- Kruk, T.; Szczepanowicz, K.; Stefańska, J.; Socha, R.; Warszyński, P. Synthesis and Antimicrobial Activity of Monodisperse Copper Nanoparticles. Colloids Surf. B Biointerfaces 2015, 128, 17–22. [Google Scholar] [CrossRef]
- Jones, N.; Ray, B.; Ranjit, K.T.; Manna, A.C. Antibacterial Activity of ZnO Nanoparticle Suspensions on a Broad Spectrum of Microorganisms. FEMS Microbiol. Lett. 2008, 279, 71–76. [Google Scholar] [CrossRef] [PubMed]
- Bruna, T.; Maldonado-Bravo, F.; Jara, P.; Caro, N. Silver Nanoparticles and Their Antibacterial Applications. Int. J. Mol. Sci. 2021, 22, 7202. [Google Scholar] [CrossRef]
- Sidorowicz, A.; Fais, G.; Casula, M.; Borselli, M.; Giannaccare, G.; Locci, A.M.; Lai, N.; Orrù, R.; Cao, G.; Concas, A. Nanoparticles from Microalgae and Their BiomedicalApplications. Mar. Drugs 2023, 21, 352. [Google Scholar] [CrossRef] [PubMed]
- Sidorowicz, A.; Yigit, N.; Wicht, T.; Stöger-Pollach, M.; Concas, A.; Orrù, R.; Cao, G.; Rupprechter, G. Microalgae-derived Co3O4 nanomaterials for catalytic CO oxidation. RSC Adv. 2024, 14, 4575–4586. [Google Scholar] [CrossRef]
- Sidorowicz, A.; Margarita, V.; Fais, G.; Pantaleo, A.; Manca, A.; Concas, A.; Rapelli, P.; Fiori, P.L.; Cao, G. Characterization of nanomaterials synthesized from Spirulina platensis extract and their potential antifungal activity. PLoS ONE 2022, 17, e0274753. [Google Scholar] [CrossRef] [PubMed]
- Jadoun, S.; Arif, R.; Jangid, N.; Meena, R. Green Synthesis of Nanoparticles Using Plant Extracts: A Review. Environ. Chem. Lett. 2021, 19, 355–374. [Google Scholar] [CrossRef]
- Radulescu, C.; Buruleanu, L.; Nicolescu, C.M.; Olteanu, R.; Bumbac, M.; Holban, G.; Simal-Gandara, J. Phytochemical Profiles, Antioxidant and Antibacterial Activities of Grape (Vitis vinifera L.) Seeds and Skin from Organic and Conventional Vineyards. Plants 2020, 9, 1470. [Google Scholar] [CrossRef]
- Pascariu, S.; Pop, I.; Simeanu, D.; Pavel, G.; Solcan, C. Effects of Wine By-Products on Growth Performance, Complete Blood Count and Total Antioxidant Status in Broilers. Rev. Bras. Ciência Avícola 2017, 19, 2. [Google Scholar] [CrossRef]
- Sirohi, R.; Tarafdar, A.; Singh, S.; Negi, T.; Gaur, V.K.; Gnansounou, E.; Bharathiraja, B. Green Processing and Biotechnological Potential of Grape Pomace: Current Trends and Opportunities for Sustainable Biorefinery. Bioresour. Technol. 2020, 314, 123771. [Google Scholar] [CrossRef]
- Gómez-Brandón, M.; Lores, M.; Insam, H. Strategies for Recycling and Valorization of Grape Marc. Crit. Rev. Biotechnol. 2019, 39, 437–450. [Google Scholar] [CrossRef] [PubMed]
- Pintać Šarac, D.; Četojević Simin, D.; Berežni, S.; Orčić, D.; Mimica-Dukic, N.; Lesjak, M. Investigation of the Chemical Composition and Biological Activity of Edible Grapevine (Vitis vinifera L.) Leaf Varieties. Food Chem. 2019, 286, 686–695. [Google Scholar] [CrossRef] [PubMed]
- Pantelić, M.; Dabić, D.; Ćirić, I.; Pergal, M.; Relic, D.; Todic, S.; Natić, M. Phenolic Profiles, Antioxidant Activity and Minerals in Leaves of Different Grapevine Varieties Grown in Serbia. J. Food Compos. Anal. 2017, 62, 76–83. [Google Scholar] [CrossRef]
- Šuković, D.; Knežević, B.; Gašić, U.; Sredojević, M.; Ćirić, I.; Todić, S.; Mutić, J.; Tešić, Ž. Phenolic Profiles of Leaves, Grapes and Wine of Grapevine Variety Vranac (Vitis vinifera L.) from Montenegro. Foods 2020, 9, 138. [Google Scholar] [CrossRef] [PubMed]
- Nzekoue, A.F.; Kouamo Nguefang, M.L.; Alessandroni, L.; Mustafa, A.; Vittori, S.; Caprioli, G. Grapevine Leaves (Vitis vinifera): Chemical Characterization of Bioactive Compounds and Antioxidant Activity during Leave Development. Food Biosci. 2022, 50, 102120. [Google Scholar] [CrossRef]
- Malandrakis, A.A.; Kavroulakis, N.; Chrysikopoulos, C.V. Zinc Nanoparticles: Mode of Action and Efficacy against Boscalid-Resistant Alternaria Alternata Isolates. Sci. Total Environ. 2022, 829, 154638. [Google Scholar] [CrossRef] [PubMed]
- Wang, X. The Comparison of Titanium Dioxide and Zinc Oxide Used in Sunscreen Based on Their Enhanced Absorption. Appl. Comput. Eng. 2023, 24, 237–245. [Google Scholar] [CrossRef]
- Tegenaw, A.B.; Yimer, A.A.; Beyene, T.T. Boosting the Photocatalytic Activity of ZnO-NPs through the Incorporation of C-Dot and Preparation of Nanocomposite Materials. Heliyon 2023, 9, e20717. [Google Scholar] [CrossRef]
- Jarosz, M.; Magdalena, O.; Wyszogrodzka, G.; Mlyniec, K.; Librowski, T. Antioxidant and Anti-Inflammatory Effects of Zinc. Zinc-Dependent NF-kB Signaling. Inflammopharmacology 2017, 25, 11–24. [Google Scholar] [CrossRef]
- Damle, M.; Mallya, R. Development and Evaluation of a Novel Delivery System Containing Phytophospholipid Complex for Skin Aging. AAPS PharmSciTech 2016, 17, 607–617. [Google Scholar] [CrossRef]
- Fattahi, S.; Zabihi, E.; Abedian, Z.; Pourbagher, R.; Ardekani, A.; Mostafazadeh, A.; Akhavan, H. Total Phenolic and Flavonoid Contents of Aqueous Extract of Stinging Nettle and In Vitro Antiproliferative Effect on Hela and BT-474 Cell Lines. Int. J. Mol. Cell. Med. 2014, 3, 102–107. [Google Scholar] [PubMed]
- Phuyal, N.; Jha, P.; Raturi, P.; Rajbhandary, S. Total Phenolic, Flavonoid Contents, and Antioxidant Activities of Fruit, Seed, and Bark Extracts of Zanthoxylum Armatum DC. Sci. World J. 2020, 2020, 8780704. [Google Scholar] [CrossRef] [PubMed]
- Ramdhan, B.; Yusuf, A. Formulation and Evaluation of Avocado Leaf Extract (Persea Americana Mill.) Cream Based on Variations Stearic Acid Concentration. Ad-Dawaa J. Pharm. 2023, 1, 78–86. [Google Scholar] [CrossRef]
- Alamier, W.M.; Hasan, N.; Ali, S.K.; Oteef, M.D.Y. Biosynthesis of Ag Nanoparticles Using Caralluma Acutangula Extract and Its Catalytic Functionality towards Degradation of Hazardous Dye Pollutants. Crystals 2022, 12, 1069. [Google Scholar] [CrossRef]
- Krysa, M.; Szymańska-Chargot, M.; Zdunek, A. FT-IR and FT-Raman Fingerprints of Flavonoids—A Review. Food Chem. 2022, 393, 133430. [Google Scholar] [CrossRef] [PubMed]
- De Souza, R.F.; De Giovani, W.F. Synthesis, Spectral and Electrochemical Properties of Al (III) and Zn (II) Complexes with Flavonoids. Spectrochim. Acta Part A Mol. Biomol. Spectrosc. 2005, 61, 1985–1990. [Google Scholar] [CrossRef]
- Panhwar, Q.K.; Memon, S. Synthesis, Characterization and Antioxidant Activity of Rutin Complexes. Pak. J. Anal. Environ. Chem. 2014, 15, 61. [Google Scholar]
- Kalinowska, M.; Swiderski, G.; Matejczyk, M.; Lewandowski, W. Spectroscopic, Thermogravimetric and Biological Studies of Na(I), Ni(II) and Zn(II) Complexes of Quercetin. J. Therm. Anal. Calorim. 2016, 126, 141–148. [Google Scholar] [CrossRef]
- Uskoković-Marković, S.; Milenković, M.; Pavun, L. Zinc-Quercetin Complex: From Determination to Bioactivity. Acta Agric. Serbica 2020, 25, 113–120. [Google Scholar] [CrossRef]
- Guo, Z. Artemisinin Anti-Malarial Drugs in China. Acta Pharm. Sin. B 2016, 6, 115–124. [Google Scholar] [CrossRef]
- Lambers, H.; Piessens, S.; Bloem, A.; Pronk, H.; Finkel, P. Natural Skin Surface pH Is on Average below 5, Which Is Beneficial for Its Resident Flora. Int. J. Cosmet. Sci. 2006, 28, 359–370. [Google Scholar] [CrossRef] [PubMed]
- Mendes, C.; Dilarri, G.; Forsan, C.; Sapata, V.; Lopes, P.; Moraes, P.; Montagnolli, R.; Ferreira, H.; Bidoia, E. Antibacterial Action and Target Mechanisms of Zinc Oxide Nanoparticles against Bacterial Pathogens. Sci. Rep. 2022, 12, 2658. [Google Scholar] [CrossRef] [PubMed]
- Sirelkhatim, A.; Mahmud, S.; Seeni, A.; Kaus, N.H.M.; Ann, L.C.; Bakhori, S.K.M.; Hasan, H.; Mohamad, D. Review on Zinc Oxide Nanoparticles: Antibacterial Activity and Toxicity Mechanism. Nano-Micro Lett. 2015, 7, 219–242. [Google Scholar] [CrossRef] [PubMed]

| Ingredients | Samples | |||||
|---|---|---|---|---|---|---|
| S1 | S2 | S3 | S4 | S5 | S6 | |
| Beeswax (g) | 2 | 2 | 2 | 2 | 2 | 2 |
| 10% (v/v) Span 80 solution in olive oil (mL) | 2.4 | 2.4 | 2.4 | 2.4 | 2.4 | 2.4 |
| Glycerol (mL) | 2.7 | 2.7 | 2.7 | 2.7 | 2.7 | 2.7 |
| 20% Tween 80 solution (mL) | 3 | 3 | 3 | 3 | 3 | 3 |
| Gelatine (g) | 1 | 1 | 1 | 1 | 1 | 1 |
| 3% chitosan solution (g) | 6 | 6 | 6 | 6 | 6 | 6 |
| VLSENPs (g) | - | 0.2 | - | - | - | - |
| ZnNPs (g) | - | - | 0.2 | 0.3 | 0.4 | 0.5 |
| Distilled water (mL) | 22.2 | 22.0 | 22.0 | 21.9 | 21.8 | 21.7 |
| Pos. (°2θ) | Intensity (cts) | FWHM (°2θ) | d-Spacing (Å) | Rel. Int. (%) | Matched | Crystallites Size [nm] |
|---|---|---|---|---|---|---|
| 12.6920 | 12,169.39 | 0.0904 | 6.97475 | 100.00 | No | 1.544441 |
| 16.6570 | 5866.62 | 0.1421 | 5.32237 | 48.21 | No | 0.986918 |
| 17.9790 | 489.56 | 0.2067 | 4.93388 | 4.02 | No | 0.679669 |
| 19.3241 | 1734.18 | 0.1034 | 4.59338 | 14.25 | No | 1.361303 |
| 20.2651 | 3212.55 | 0.2326 | 4.38217 | 26.40 | No | 0.606021 |
| 22.5084 | 2160.16 | 0.1809 | 3.95024 | 17.75 | No | 0.782104 |
| 23.6635 | 1425.45 | 0.2067 | 3.75996 | 11.71 | No | 0.685893 |
| 25.3401 | 2143.02 | 0.2067 | 3.51486 | 17.61 | No | 0.688076 |
| 27.6706 | 1418.89 | 0.1809 | 3.22390 | 11.66 | No | 0.789984 |
| 28.4806 | 806.80 | 0.2067 | 3.13403 | 6.63 | No | 0.692603 |
| 31.6977 | 318.05 | 0.3101 | 2.82291 | 2.61 | No | 0.465158 |
| 33.5606 | 441.25 | 0.2584 | 2.67035 | 3.63 | No | 0.560888 |
| 35.9833 | 77.10 | 0.4134 | 2.49592 | 0.63 | No | 0.352917 |
| 37.3235 | 226.71 | 0.5168 | 2.40932 | 1.86 | No | 0.283402 |
| 38.4623 | 357.03 | 0.3101 | 2.34057 | 2.93 | No | 0.473921 |
| 39.3922 | 114.44 | 0.3101 | 2.28743 | 0.94 | No | 0.475282 |
| 42.4444 | 225.03 | 0.7235 | 2.12974 | 1.85 | No | 0.205746 |
| 44.7317 | 335.42 | 0.1550 | 2.02602 | 2.76 | No | 0.968063 |
| 45.6036 | 242.96 | 0.3101 | 1.98929 | 2.00 | No | 0.485409 |
| 46.5195 | 201.67 | 0.3101 | 1.95223 | 1.66 | No | 0.487061 |
| 47.4308 | 160.12 | 0.3101 | 1.91683 | 1.32 | No | 0.488748 |
| 51.9975 | 127.01 | 0.5168 | 1.75872 | 1.04 | No | 0.298733 |
| 54.6402 | 109.77 | 0.4134 | 1.67974 | 0.90 | No | 0.377802 |
| 65.0543 | 609.61 | 0.0945 | 1.43258 | 5.01 | No | 1.741569 |
| 65.2281 | 317.75 | 0.1103 | 1.43274 | 2.61 | No | 1.493543 |
| 78.1822 | 457.02 | 0.0945 | 1.22162 | 3.76 | No | 1.891892 |
| 78.4221 | 208.62 | 0.0630 | 1.22151 | 1.71 | No | 2.842678 |
| 99.1050 | 22.74 | 0.7563 | 1.01222 | 0.19 | No | 0.282812 |
| 111.9650 | 71.82 | 0.1891 | 0.92934 | 0.59 | No | 1.311658 |
| 116.5449 | 56.58 | 0.2521 | 0.90564 | 0.46 | No | 1.046672 |
| S1 | S2 | S3 | S4 | S5 | S6 | |
|---|---|---|---|---|---|---|
| Appearance | homogeneous semisolid emulsion | homogeneous semisolid emulsion | homogeneous semisolid emulsion | homogeneous semisolid emulsion | homogeneous semisolid emulsion | homogeneous semisolid emulsion |
| Color | light yellow | lighter reddish brown | darker reddish brown | darker reddish brown | darker reddish brown | darker reddish brown |
| Stability | Stable | Stable | Stable | Stable | Stable | Stable |
| Texture | Smooth | Smooth | Smooth | Smooth | Smooth | Smooth |
| Odor | Characteristic | Characteristic | Characteristic | Characteristic | Characteristic | Characteristic |
| pH * | 4.96 ± 0.15 | 5.3 ± 0.12 | 4.97 ± 0.11 | 5.1 ± 0.14 | 5.25 ± 0.11 | 5.24 ± 0.13 |
| Viscosity (Pa∙s) * | ||||||
| 0 months | 22 ± 0.65 | 24 ± 0.74 | 14 ± 0.43 | 16.25 ± 0.50 | 16.50 ± 0.51 | 16.50 ± 0.51 |
| 1 month | 15.25 ± 0.44 | 23.25 ± 0.67 | 13.75 ± 0.40 | 16.25 ± 0.47 | 16.50 ± 0.48 | 16.50 ± 0.48 |
| 3 months | 9.50 ± 0.31 | 23 ± 0.76 | 13.75 ± 0.45 | 16.25 ± 0.53 | 16.50 ± 0.54 | 16.50 ± 0.54 |
| 6 months | - | 23 ± 0.78 | 13.75 ± 0.47 | 16.25 ± 0.55 | 16.50 ± 0.56 | 16.50 ± 0.56 |
| 9 months | - | 23 ± 0.82 | 13.75 ± 0.54 | 16.25 ± 0.62 | 16.50 ± 0.44 | 16.50 ± 0.58 |
| 12 months | - | - | 13.75 ± 0.49 | 16.25 ± 0.58 | 16.50 ± 0.53 | 16.50 ± 0.55 |
| Spreading diameters (cm) * | ||||||
| 0 months | 5.66 ± 0.12 | 5.54 ± 0.11 | 5.71 ± 0.12 | 5.24 ± 0.11 | 5.23 ± 0.11 | 5.23 ± 0.11 |
| 1 month | 6.62 ± 0.15 | 5.59 ± 0.13 | 5.74 ± 0.13 | 5.24 ± 0.12 | 5.23 ± 0.12 | 5.23 ± 0.12 |
| 3 months | 6.79 ± 0.14 | 5.62 ± 0.12 | 5.75 ± 0.13 | 5.24 ± 0.12 | 5.23 ± 0.12 | 5.23 ± 0.11 |
| 6 months | - | 5.66 ± 0.13 | 5.75 ± 0.14 | 5.25 ± 0.13 | 5.25 ± 0.12 | 5.25 ± 0.13 |
| 9 months | - | 5.66 ± 0.14 | 5.75 ± 0.18 | 5.25 ± 0.15 | 5.25 ± 0.13 | 5.25 ± 0.13 |
| 12 months | - | - | 5.75 ± 0.14 | 5.25 ± 0.13 | 5.25 ± 0.11 | 5.25 ± 0.13 |
| Microbial Strains | Zones of Inhibition (mm) Mean ± SD | ||||||
|---|---|---|---|---|---|---|---|
| Cream Samples | |||||||
| S1 | S2 | S3 | S4 | S5 | S6 | ||
| Gram-positive Bacteria | Staphylococcus aureus ATCC 25923 | 0 | 0 | 0 | 2.3 ± 0.3 | 3.6 ± 0.3 | 4.3 ± 0.3 |
| Methicillin-resistant Staphylococcus aureus (MRSA) ATCC 33591 | 0 | 0 | 0 | 1.3 ± 0.3 | 3 ± 0 | 4.3 ± 0.3 | |
| Gram-negative Bacteria | Escherichia coli ATCC 25922 | 0 | 0 | 0 | 0 | 3 ± 0 | 4.3 ± 0.3 |
| Yeast | Candida albicans ATCC 90028 | 0 | 0 | 0 | 0 | 2.3 ± 0.3 | 2.6 ± 0.3 |
Disclaimer/Publisher’s Note: The statements, opinions and data contained in all publications are solely those of the individual author(s) and contributor(s) and not of MDPI and/or the editor(s). MDPI and/or the editor(s) disclaim responsibility for any injury to people or property resulting from any ideas, methods, instructions or products referred to in the content. |
© 2024 by the authors. Licensee MDPI, Basel, Switzerland. This article is an open access article distributed under the terms and conditions of the Creative Commons Attribution (CC BY) license (https://creativecommons.org/licenses/by/4.0/).
Share and Cite
Muresan, E.I.; Pui, A.; Cernatescu, C.; Cimpoesu, R.; Horhogea, C.E.; Istrate, B.; Rîmbu, C.M. Green Synthesis of Nanoparticles Containing Zinc Complexes and Their Incorporation in Topical Creams with Antimicrobial Properties. Appl. Sci. 2024, 14, 4612. https://doi.org/10.3390/app14114612
Muresan EI, Pui A, Cernatescu C, Cimpoesu R, Horhogea CE, Istrate B, Rîmbu CM. Green Synthesis of Nanoparticles Containing Zinc Complexes and Their Incorporation in Topical Creams with Antimicrobial Properties. Applied Sciences. 2024; 14(11):4612. https://doi.org/10.3390/app14114612
Chicago/Turabian StyleMuresan, Emil Ioan, Aurel Pui, Corina Cernatescu, Ramona Cimpoesu, Cristina Elena Horhogea, Bogdan Istrate, and Cristina Mihaela Rîmbu. 2024. "Green Synthesis of Nanoparticles Containing Zinc Complexes and Their Incorporation in Topical Creams with Antimicrobial Properties" Applied Sciences 14, no. 11: 4612. https://doi.org/10.3390/app14114612
APA StyleMuresan, E. I., Pui, A., Cernatescu, C., Cimpoesu, R., Horhogea, C. E., Istrate, B., & Rîmbu, C. M. (2024). Green Synthesis of Nanoparticles Containing Zinc Complexes and Their Incorporation in Topical Creams with Antimicrobial Properties. Applied Sciences, 14(11), 4612. https://doi.org/10.3390/app14114612

